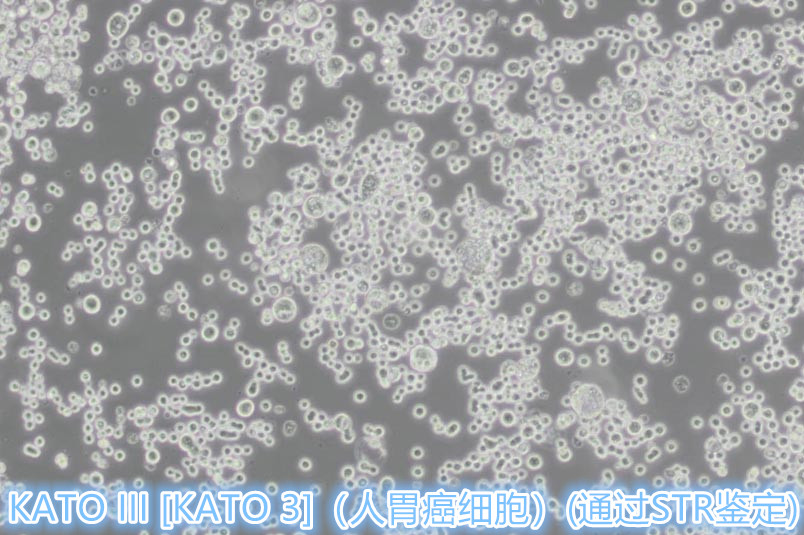
产品细节图片1

相关产品推荐更多 >
万千商家帮你免费找货
0 人在求购买到急需产品
- 详细信息
- 文献和实验
- 技术资料
- 库存:
充足
- 供应商:
武汉研升生物科技有限公司
- 规格:
1×10⁶cells/T25培养瓶
KATO III [KATO 3](人胃癌细胞)产品信息
| 名称 | KATO III [KATO 3] (人胃癌细胞) (STR鉴定正确) |
| 别称 | Kato III; Kato-III; KATO-III; KATOIII; KatoIII; KATO 3; JTC-28; Japanese Tissue Culture-28 |
| 种属 | 人 |
| 年龄(性别) | 男;55岁 |
| 组织来源 | 器官:胃;疾病:胃癌;取材转移灶:胸水、锁骨及腋窝淋巴结和道格拉斯氏陷凹 |
| 生长特性 | 半贴半悬 |
| 细胞形态 | 上皮细胞样 |
| 细胞类型 | 肿瘤细胞 |
| 肿瘤类型 | 胃癌细胞 |
| 生物安全等级 | 1 |
| 生长培养基 | IMDM+10% FBS+1% P/S |
| 推荐传代比例 | 1:2-1:4 |
| 推荐换液频率 | 2~3次/周 |
| 倍增时间 | ~32-36 hours |
| 冻存条件 | 冻存液:55% 基础培养基+40%FBS+5%DMSO 温度:液氮 |
| 培养条件 | 气相:空气,95%;CO2,5% 温度:37℃ |
| 致瘤性 | Yes, in cheek pouches of anti thymocyte serum treated hamsters.No, in nude mice. |
KATO III [KATO 3](人胃癌细胞)培养图片
风险提示:丁香通仅作为第三方平台,为商家信息发布提供平台空间。用户咨询产品时请注意保护个人信息及财产安全,合理判断,谨慎选购商品,商家和用户对交易行为负责。对于医疗器械类产品,请先查证核实企业经营资质和医疗器械产品注册证情况。
文献和实验,它使区分活跃寄生虫和聚集地(如青少年寄生虫体内剩余的后处理,可能不会产生卵子,这些需要一个多星期到期)。什么时候黄金标准不是黄金标准?关于肠血吸虫病的公共卫生政策决定是基于Kato-Katz计算的患病率,然而,如果更好地理解Kato-Katz和CCA在治疗前和治疗后的关系,CCA正越来越多地用于绘制疾病地图,并可用于制定政策。普拉达和他的同事因此建立了流行率和强度的关系模型,这是根据Kato-Katz和来自乌干达Mayuge区的儿童在三个时间点的结果判断出来的:治疗前、治疗后1个月和治疗后6个月
Overexpression and Purification of Bacterial Topoisomerase IV
Escherichia coli topoisomerase IV (topo IV) was discovered by Kato et al. (1 ), who showed that the predicted open reading frames from the parC and parE genes encoded proteins with a high degree of amino acid similarity to gyrA and gyrB
(1988).5)Einhauer, A. et al. : J. Biochem. Biophys.Methods, 49, 455-465 (2001).6)Kato, Y. et al. : Cancer Sci., 99, 54-61 (2008).7)Kato, Y. et al. : Biochem. Biophys. Res.Commun., 349, 1301-1307 (2006).8)Kaneko, M. K. et al. : Cancer Sci., 103, 1913-1919
技术资料暂无技术资料 索取技术资料




](https://img1.dxycdn.com/p/s14/2026/0324/377/6100539941153826302.jpg!wh200)

